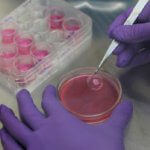
Laboruntersuchung

Die Auszeichnung nahm Arun Chandru, Mitbegründer des Unternehmens entgegen. Er zeigte sich begeistert und geehrt, von dieser hervorragend besetzten Jury ausgezeichnet zu werden. „Es war eine spannende Reise für uns – Zeuge und Teil dieser teleskopischen Entwicklung von Startups in Indien zu sein. Ich bin mir sicher, dass die kommenden Zeiten noch spannender werden.“ Besonders hob er das Bangalore Bioinnovation Center und die Association of Biotech Led Enterprises hervor.

Pandorum war das erste Unternehmen in Indien, das menschliches Lebergewebe für die medizinische Forschung entwickelte und mittels 3D-Druck herstellte. Gegründet wurde es im Jahr 2011 in Bangalore. Es legt seinen Fokus auf die Gewebeentwicklung und die regenerative Medizin.
Derzeit forscht das interdisziplinäre Team an der Entwicklung einer biotechnischen menschlichen Hornhaut, welche implantiert werden kann. Die 3D-gedruckten menschlichen Gewebe Pandorums können sowohl in der medizinischen Forschung und für Tests neuer Medikamente auf deren Wirksamkeit eingesetzt werden. Zu den Visionen Pandorums gehört es, personalisierte menschliche Organe wie beispielsweise Lungen herstellen zu können.

Unterstützung erfährt Pandorum Technologies unter anderem vom Biotechnology Industry Research Assistance Council. Seine Labore befinden sich aktuell im Centre for Cellular and Molecular Platforms auf dem Campus des National Centre for Biological Sciences und im Bangalore Bioinnovation Centre, beide sind in Bengaluru ansässig.
In diesem Monat berichteten wir bereits darüber, dass auch spanische Forscher an der Erforschung einer neuen Hornhaut für das Auge arbeiten. Chinesische Forscher stellten bereits im Jahr 2015 eine Ersatzhornhaut für das Auge her.